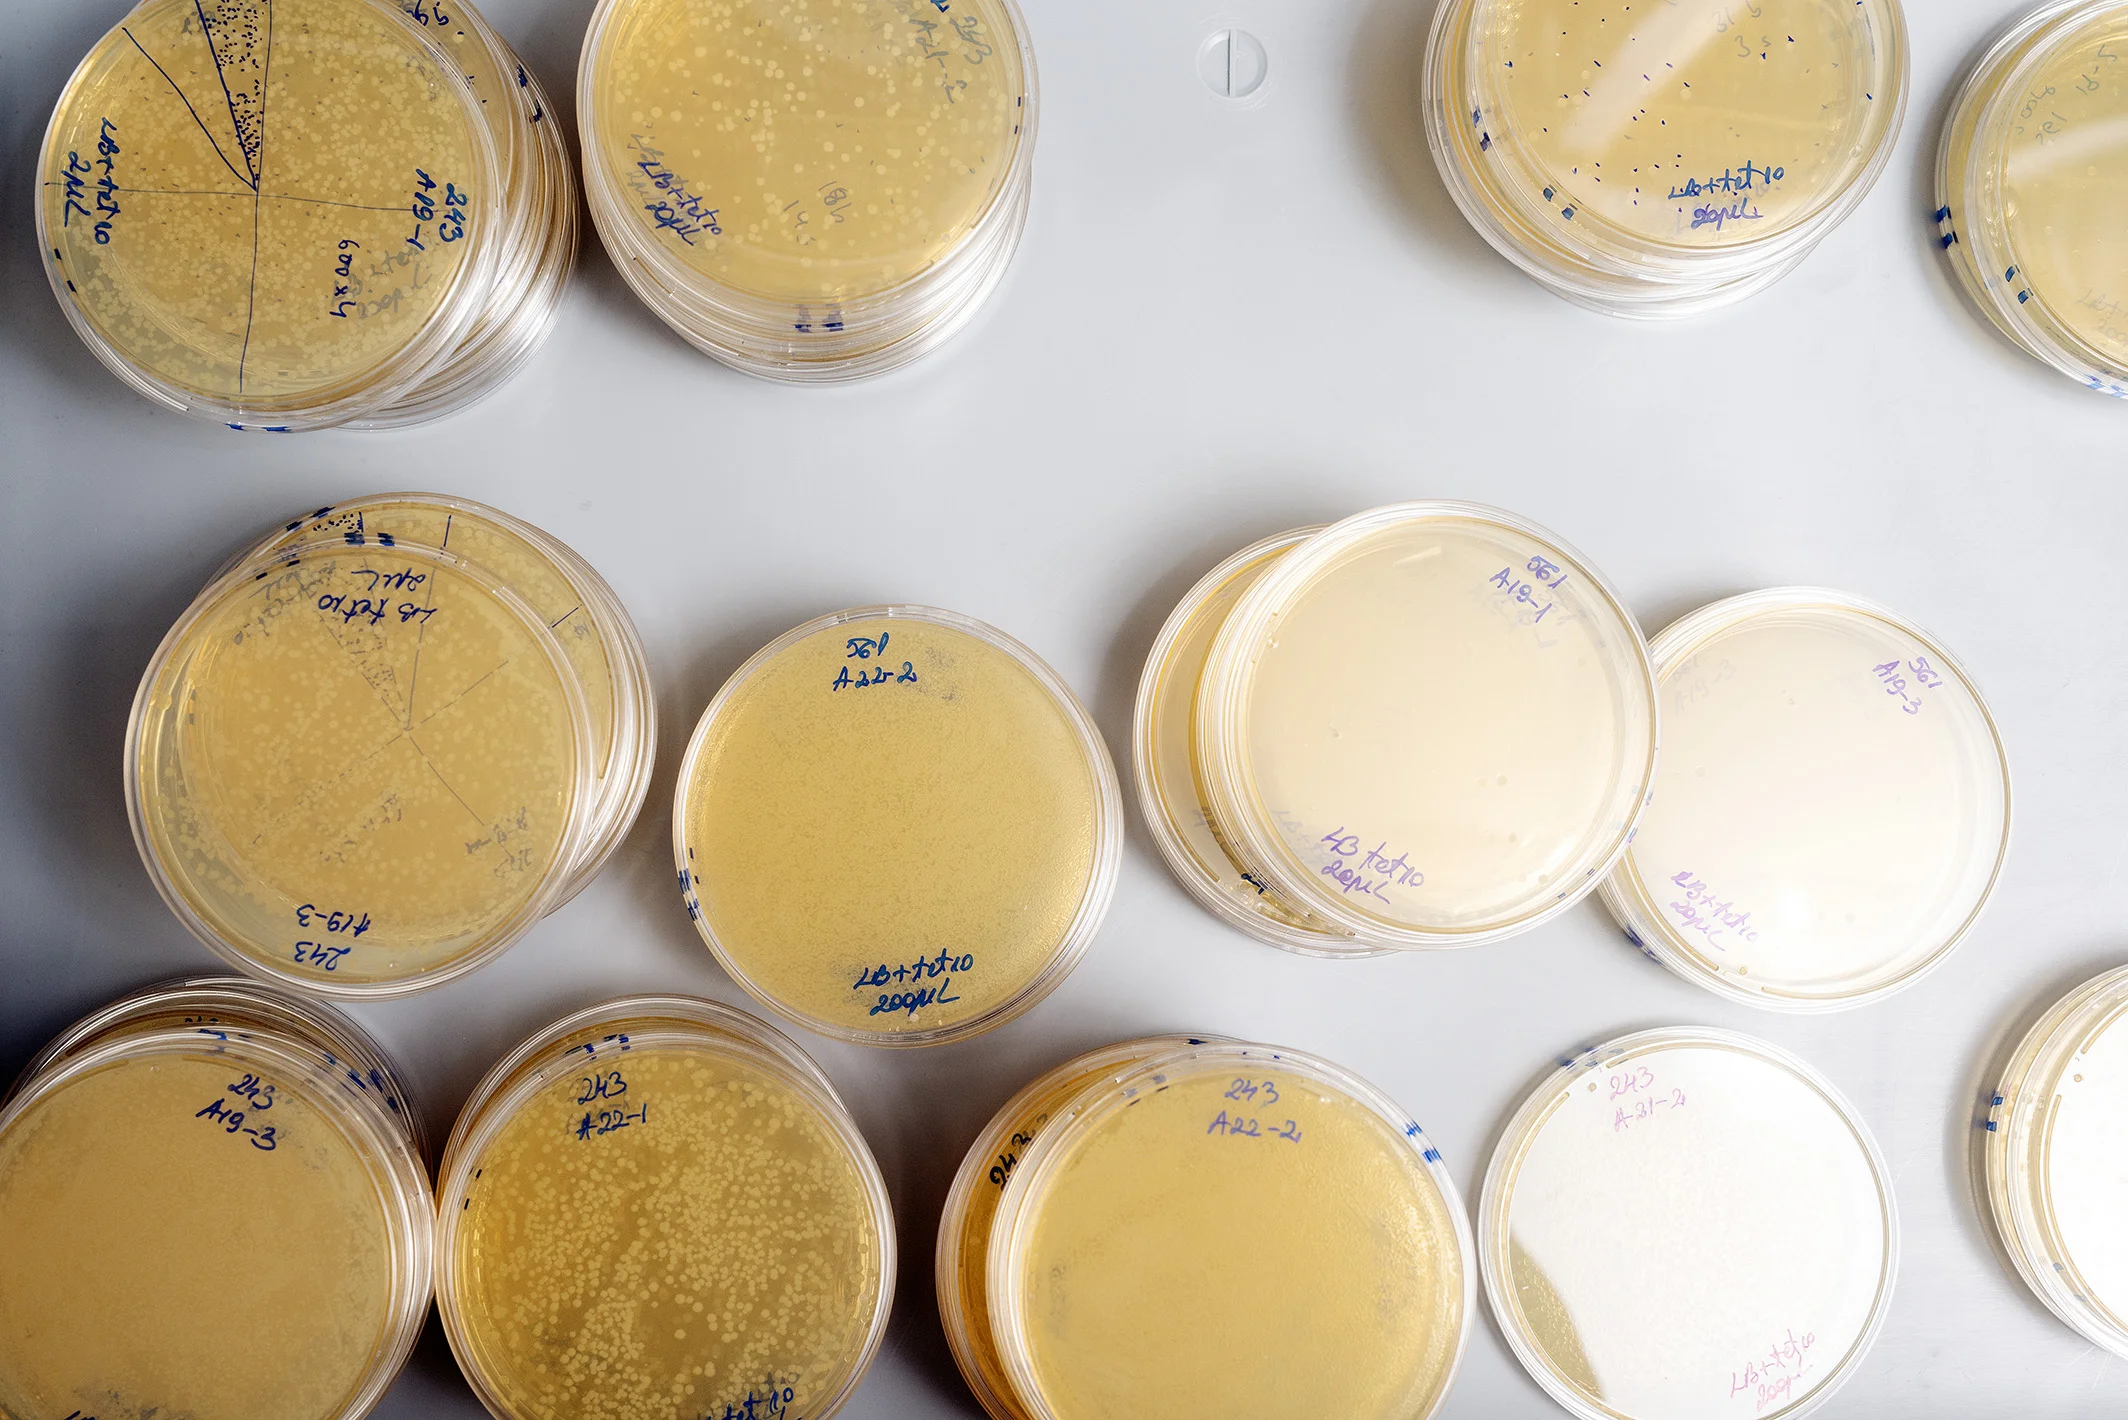

Publications
Our Granted Patents
04.21.2020
Altering microbial populations and modifying microbiota (US10624349)
03.31.2020
Selectively Altering Microbiota for Immune Modulation (US10603379)
03.24.2020
Selectively Altering Microbiota for Immune Modulation (US10596255)
03.10.2020
Altering microbial populations and modifying microbiota (US10582712)
02.18.2020
Altering microbial populations and modifying microbiota (US10561148)
01.07.2020
Altering microbial populations and modifying microbiota (US10524477)
12.17.2019
Altering Microbial Populations and Modifying Microbiota (US10506812)
11.30.2019
Altering Microbial Populations and Modifying Microbiota (US10463049)
07.30.2019
Selectively Altering Microbiota for Immune Modulation (US10363308)
05.28.2019
Selectively Altering Microbiota for Immune Modulation (US10300138)
05.28.2019
Selectively Altering Microbiota for Immune Modulation (US10300139)
02.05.2019
Selectively Altering Microbiota for Immune Modulation (US10195273)
07.11.2017
Altering Microbial Populations and Modifying Microbiota (US9701964)
